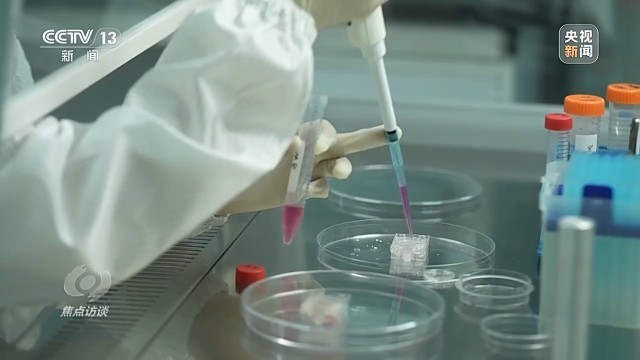

7月15日的清晨,在文昌卫星发射场,长征七号遥十运载火箭搭载着天舟九号货运飞船从这里出发前往太空,3个小时以后,天舟快递顺利到站。这已经是4年多以来,天舟货运飞船第8次为中国空间站送货。从文昌出发,一条从地球前往太空的快捷物流通道已经搭建完毕。那么,这样的一个太空货运系统究竟是怎么构筑起来的?它有着怎样的意义?接下来又会有怎样的发展呢?

7月15日下午3点40分左右,正在太空出差的中国航天员打开刚刚到站的天舟九号货运飞船舱门,开始查收从地面送来的包裹。就在当天早上,天舟九号才刚从海南文昌出发。半天时间,就能收到天舟货船从地面运到太空的货物,这是今天中国航天员在中国空间站才能享受到的宇宙专送。那么,这样一条天地快速物流通道,究竟是怎么搭建的?不妨让我们把时针往前拨,看看天舟九号完成这样的宇宙快送,究竟经历了哪些过程。

飞天前2个月,天舟九号货运飞船已经到达海南,此时,货船内还没放置太多货物,剩下的物资会在发射场接收装货。对现在的天舟飞船来说,只要货物总重量不超过7.4吨,飞船工程师们会在22.5立方米的空间内尽量把它们都安置好。

中国航天科技集团 张振华:天舟九号这次货物物资的运输量是6.5吨,是整个空间站应用与发展阶段以来,物资量运输最大的一次。这次的货运量相对于天舟八号有大概11%的提升,固态货物、气态货物、液态货物都有,货物种类非常全,还有特别大件的货物。

在这些大件里,国产舱外航天服是这次任务需要特殊关注的货物。和普通货包相比,它体积大、怕挤压,不能直接放在货架上,需要特殊手段保证运送“零磕碰”。

妥善打包、按需排布,只是天舟货运飞船众多看家本领中的一项。从天舟一号开始,天舟系列飞船逐步验证了货物运输、推进剂在轨补加、快速交会对接等多项关键技术,2017年以来,经过9次任务,如今,中国航天科技集团五院抓总研制的天舟货运飞船已经跻身世界最强太空货运飞船之列。这次发射的天舟九号飞船,首次具备了3个月应急发射能力,能够实现发一、备一的模式。

中国航天科技集团 白明生:空间站的航天员在天上工作生活,包括实验装置、实验样品也需要更换,空间站运行,物资供应保障必须是持续稳定不能中断的状态,发射天舟九号,天舟十号在北京我们已经备份好了,保证我们的任务持续无缝衔接。

天舟飞船装货基本完毕后,在文昌航天发射场的总装厂房内,和长征七号火箭合二为一,出征的脚步就在眼前。
7月12日,长征七号遥十运载火箭和天舟九号飞船从总装厂房垂直转运至发射塔架。能够用一发绿色、可靠的火箭保证中国空间站物资运行的畅通,是航天科技集团一院火箭设计师陈风雨和他同事们的梦想。2011年,长征七号火箭启动研制,考虑到发射天舟任务的火箭会从海南出发,这里高温、多雨,空气湿度大、盐度高,设计之初,火箭工程师们就做了周密的准备。

利用全数字化设计手段,长征七号是我国第一个实现设计、生产和组装全流程三维化的火箭,但是从图纸到现实,各个零件的生产到组装,再到发射场的测试,都需要磨合。

中国航天科技集团 陈风雨:长征七号火箭近些年在首飞以后,一直强调要实现流程精细化管理。每位同志工作的时候有个平板,通过平板我们往里面装进去系统,系统按照工作流程、工作岗位进行详细梳理,在发射场每一个岗位,我们都已经实现了这样一个效果。

更精细的管理,实现了对每一次发射任务更精准的把握,也磨合出了新的工作流程。空间站开建时,长征七号火箭在文昌航天发射场厂房内的准备工作还需要38天,在和发射场系统的合作下,到现在已经缩减到了25天;与此同时,临发射前的核心任务准备时间从24小时缩减到了8小时,还把原本一分一秒都不能差的“零窗口”发射,争取到了120秒的可控延迟。

7月14日,天舟九号飞船发射前11小时,发射前的最后时刻,最后一批货包登船了。每一次飞船关门前最后上船的都是生鲜特送,既有航天员的最爱,各类水果,也有需要低温保存的生命科学研究样本。这次最后登上天舟九号货船的三个科学实验样本中,有一个装在信用卡大小装置里的脑类器官芯片,它第一次将微型脑类器官模型送入太空,希望揭开空间环境影响人类大脑的秘密。

中国科学院大连化学物理研究所研究员 秦建华:宇航员在太空环境中长期驻留,容易出现头晕睡眠障碍,甚至认知功能改变等神经系统的症状,但是空间特殊环境,比如微重力、辐射等因素,如何影响脑功能的具体机制还不清楚。所以这次计划上行的脑类器官芯片,也是希望可以探究空间环境在细胞、组织、器官等多层次对人脑结构功能的影响和潜在的机理,并为宇航员在太空中长期驻留作业提供健康风险的预测与干预手段。

随着空间站进入应用与发展阶段,科学实验和试验载荷设备在货物中的比例越来越高,类似细胞、器官芯片这样的活性样本在临发射前也需要专门进行制备。从天舟九号飞船开始,科学家可以在太空实验室的文昌基地开展这项专业的工作,搭乘天舟货船去往太空的实验准备也迎来了新的流程。
像细胞这类有特殊储存环境要求的样品,必须在发射前才能装入最后的实验装置。这一次新实验室落成,为各类科学实验,尤其是生命科学类实验提供了很大便利。中国科学院上海营养与健康研究所研究员应浩此次的研究项目是太空微重力环境如何影响骨骼肌前体细胞的迁移,他希望找到抵抗肌肉萎缩的方法,这是他第二次将实验对象送上太空。

7月15日清晨,长征七号遥十火箭准时点火,按照计划将天舟九号送到预定轨道。3个多小时后,天舟九号货运飞船与空间站组合体稳稳对接,再一次验证了航天器交会对接“千里穿针”的中国水准。
天舟快送任务进入常态化,但是航天人的探索并没有到此为止。在保障送货到站的同时,无论是天舟飞船还是长七火箭,这一次还都携带了新的试验件。不仅探索空间站货运的更高可靠性,也为后续中国航天更远的目标积蓄力量。

中国航天科技集团 陈风雨:这次发射我们搭载了智慧控制的一个小系统,简单说就是给火箭请了一个飞行中的医生,及时对它的血压、体温等等各种参数进行判断,如果有异常,我们就请它来帮忙,通过控制飞行的轨迹,确保火箭哪怕带着故障,也依然能够把飞船送入预定轨道,这回看看我们设计的这套程序在天上能否正常工作。

中国航天科技集团 张振华:这次搭载了两项新型试验载荷开展在轨试验,一个是太空测距的装置,类似于现在船上装的激光雷达,但是它是新一代的;另外一个是一种新型推进试验装置,验证一种新型的推进技术,这些属于比较新型的或者前沿一点的空间技术。利用天舟货运飞船搭载支持能力去开展这样的试验,相当于在完成物资保障任务同时,有助于咱们新型空间技术的一个突破。

除了成熟的天舟货运飞船外,我国小型货运工具轻舟货运飞船和昊龙货运航天飞机方案也已经开始进入实际飞行验证阶段,今后中国载人航天“天地货运”将构建起更灵活、更多元的物流体系。
在文昌的火箭发射观看平台上,可以清楚地看到,一边是文昌航天发射场的塔架,另外一边是海南商业航天发射场的塔架。未来几年,还会有更多的中国航天器从这片椰林之间出发,奔赴太空,为我们探索宇宙带去更多的物资、更丰富的装备,同时也推动中国航天不断地走向星辰大海的深处,为我们揭开更多的宇宙奥秘。





 京公网安备 11010102004843号
京公网安备 11010102004843号